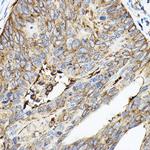
ROCK2 Antibody in Immunohistochemistry (Paraffin) (IHC (P))

Search
Invitrogen
ROCK2 Polyclonal Antibody
{{$productOrderCtrl.translations['antibody.pdp.commerceCard.promotion.promotions']}}
{{$productOrderCtrl.translations['antibody.pdp.commerceCard.promotion.viewpromo']}}
{{$productOrderCtrl.translations['antibody.pdp.commerceCard.promotion.promocode']}}: {{promo.promoCode}} {{promo.promoTitle}} {{promo.promoDescription}}. {{$productOrderCtrl.translations['antibody.pdp.commerceCard.promotion.learnmore']}}

Please note: We are reviewing Western blot images included in the antibody testing data in our catalog, including those provided by third parties. Unless expressly labeled or annotated as “raw-unedited”, Western blot images included in the antibody testing data in our catalog may have been edited, optimized or otherwise adjusted for presentation.
产品信息
PA5-96400
种属反应
宿主/亚型
分类
类型
抗原
偶联物
形式
浓度
规格
纯化类型
保存液
内含物
保存条件
运输条件
RRID
产品详细信息
Immunogen sequence: LDSKDSDIEQ LRSQLQALHI GLDSSSIGSG PGDAEADDGF PESRLEGWLS LPVRNNTKKF GWVKKYVIVS SKKILFYDSE QDKEQSNPYM VLDIDKLFHV RPVTQTDVYR ADAKEIPRIF QILYANEGES KKEQEFPVEP VGEKSNYICH KGHEFIPTLY HFPTNCEACM KPLWHMFKPP PALECRRCHI KCHKDHMDKK EEIIAPCKVY YDISTAKNLL LLANSTEEQQ KWVSRLVKKI PKKPPAPDPF ARSSPRTSMK IQQNQSIRRP SRQLAPNKPS; Positive Samples: HepG2, HT-29, ES-2, U-937, U-87MG, Mouse lung, Mouse heart; Cellular Location: Cell membrane, Cytoplasm, Nucleus, Peripheral membrane protein, centrosome, cytoskeleton, microtubule organizing center
靶标信息
ROCK2, the predominant ROCK isoform in skeletal muscle, is an important regulator downstream of Rho GTPases. ROCK2 regulates cytokinesis, smooth muscle contraction, the formation of actin stress fibers and focal adhesions, and the activation of the c-fos serum response element. This protein, which is an isozyme of ROCK1 is a target for the small GTPase Rho.
仅用于科研。不用于诊断过程。未经明确授权不得转售。
篇参考文献 (0)
生物信息学
蛋白别名: p150 ROK-alpha; p164 ROCK-2; Rho-associated coiled-coil forming kinage 2; Rho-associated coiled-coil forming kinase 2; Rho-associated protein kinase 2; Rho-associated, coiled-coil-containing protein kinase 2; Rho-associated, coiled-coil-containing protein kinase II; RhoA - binding serine/threosine kinase alpha (ROK - alpha); RhoA-binding kinase 2; ROCK II; ROCK-II; rockii; ROKalpha
基因别名: B230113H15Rik; mKIAA0619; Rho-kinase; ROCK-II; Rock2; Rock2m; ROK; ROKalpha
UniProt ID: (Rat) Q62868, (Mouse) P70336
Entrez Gene ID: (Rat) 25537, (Mouse) 19878




